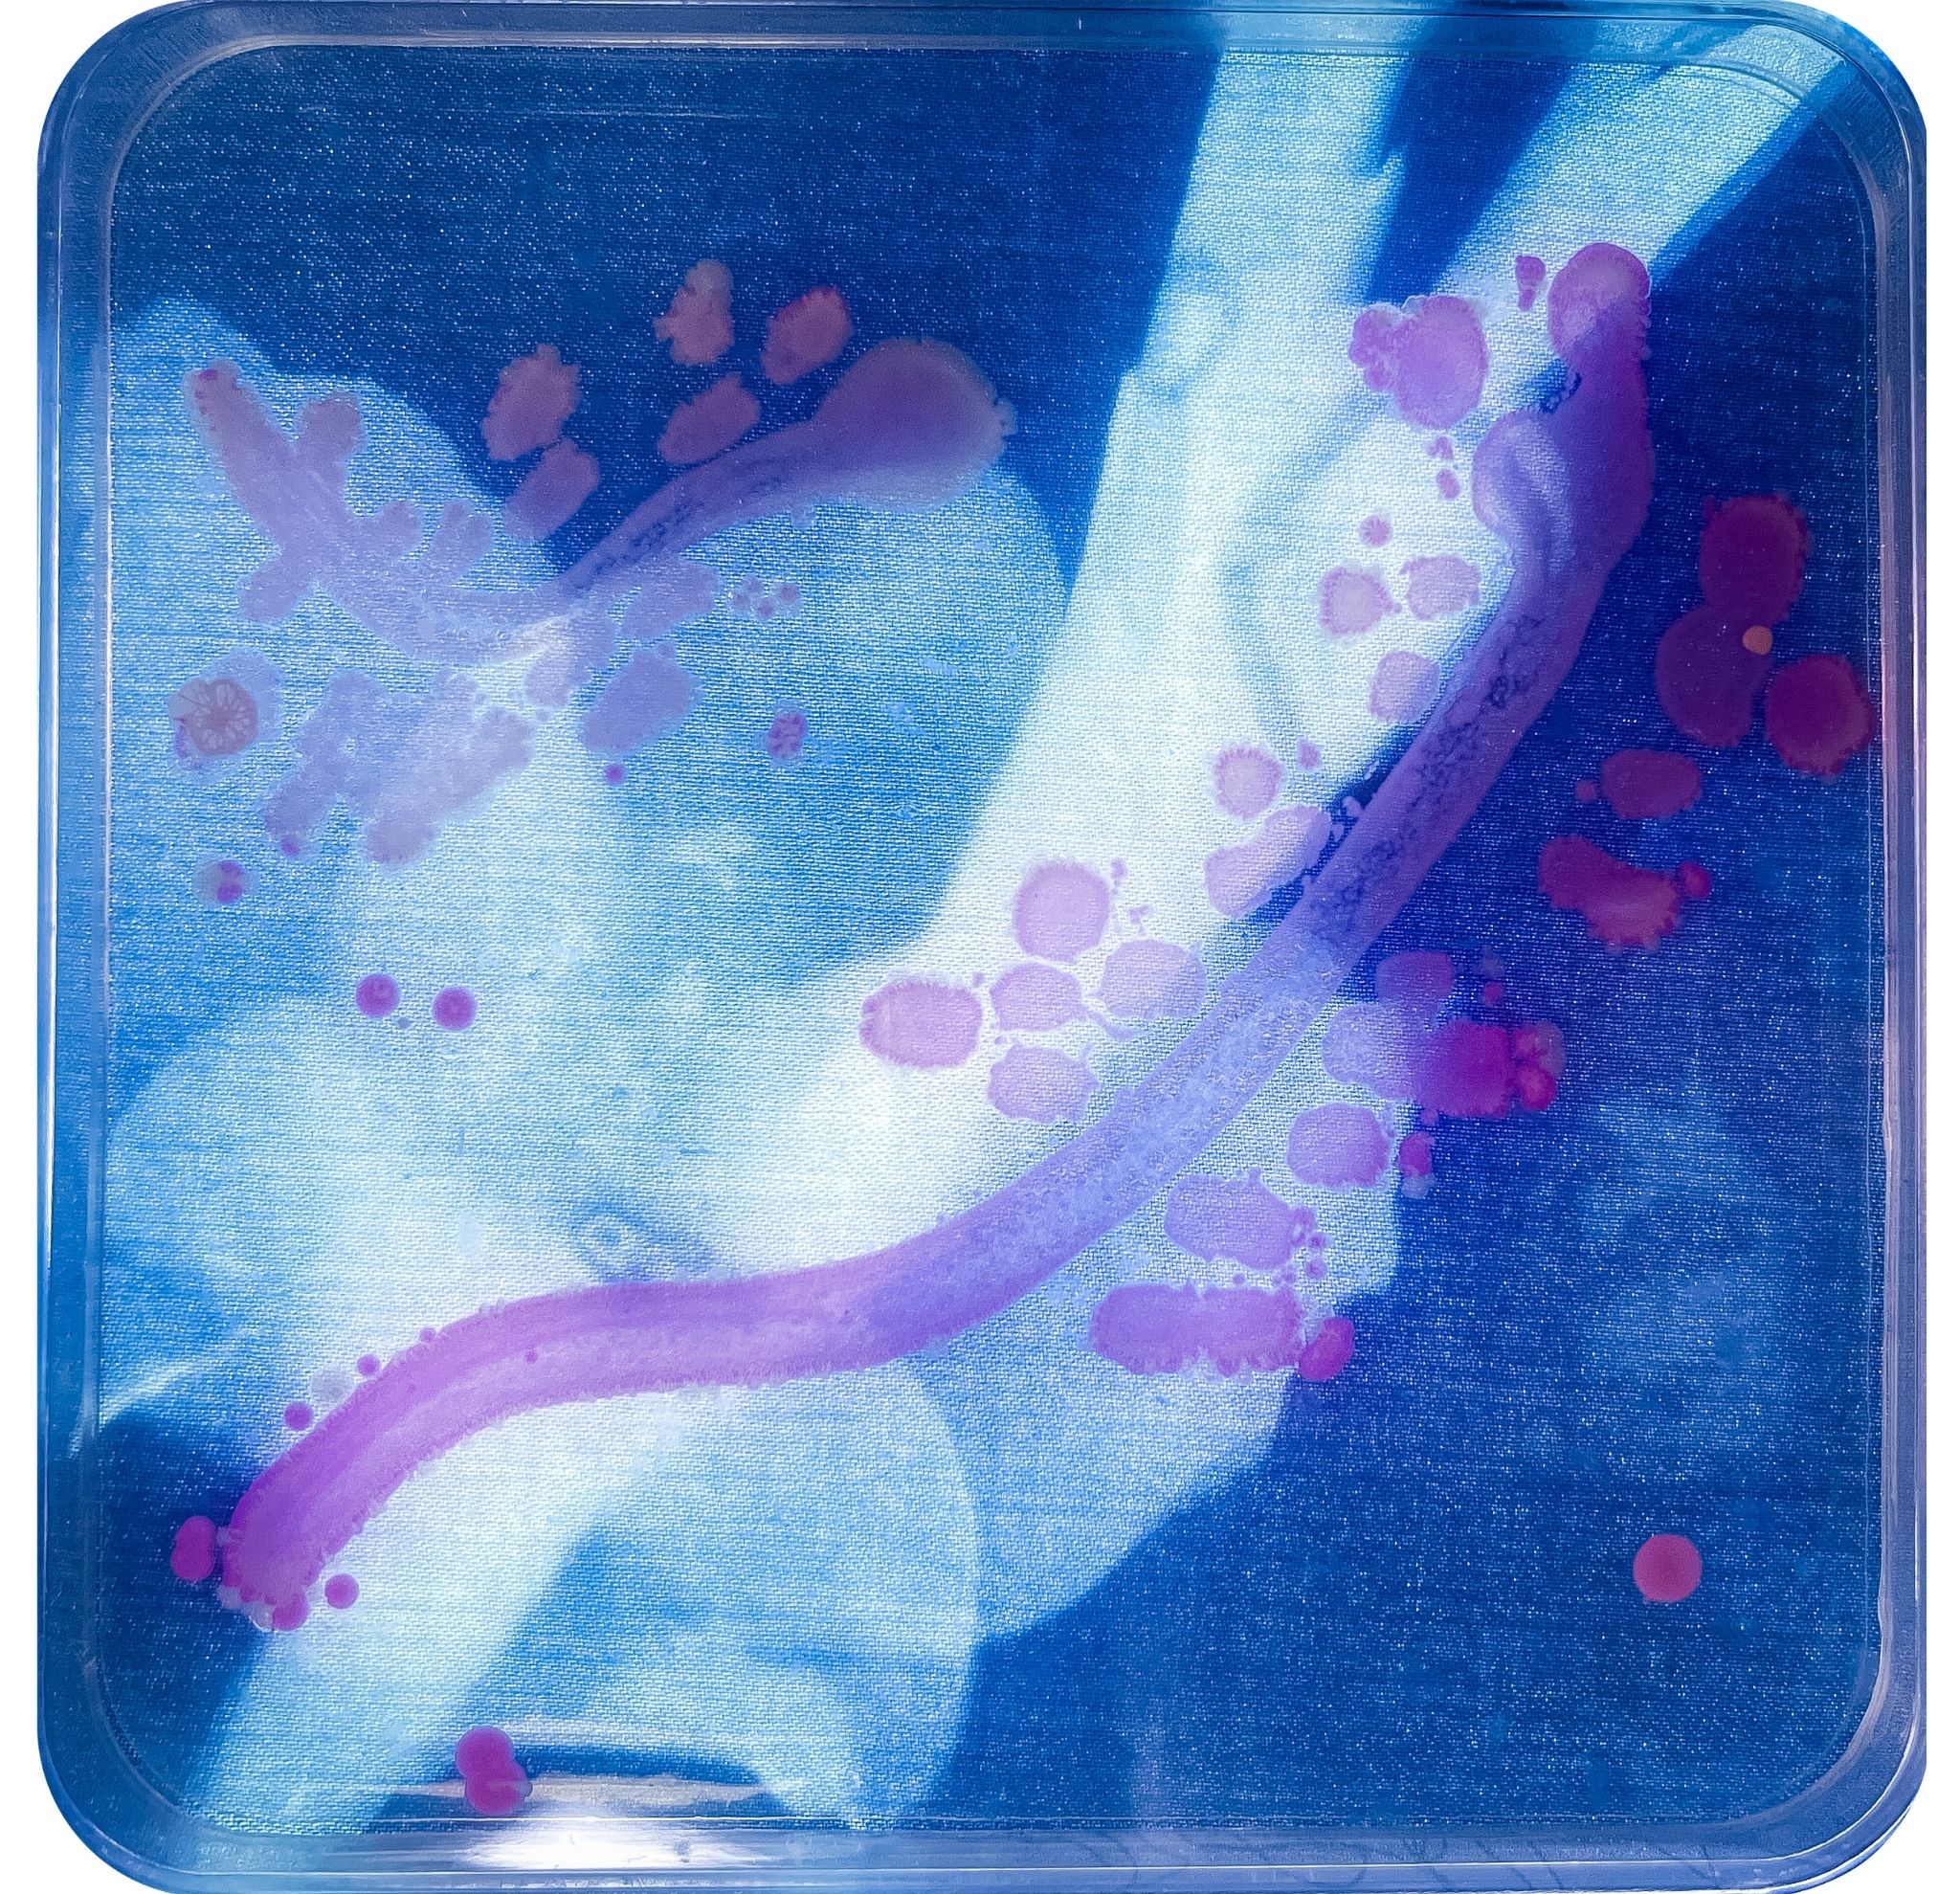

Cri Kosti is a visual artist, INCUBATOR Art Lab Research Assistant, and student at the University of Windsor. During the summer of 2025, Cri completed an independent study course with Dr. Jennifer Willet.
Hello, my name is Cri. I am an intermedia artist based in Windsor, Ontario. I focused on slow art processes within bioart, analogue filmmaking, photography, printmaking, and sculpture. My project centers on learning protocols in the lab, nurturing new gardens at home, and letting experiments with cyanotypes, bacteria painting, and other mediums develop in their own time.
Click the image below to flip through the field notes

Image Credits:
Cri Kosti, 2025.